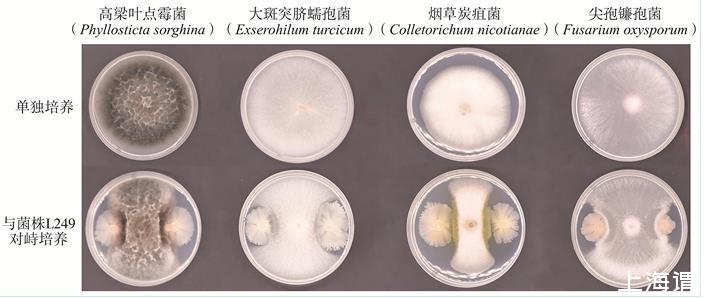

拮抗菌生長曲線測定、鑒定及對煙草赤星病室內防治效果(二)
2結果與分析
2.1拮抗菌的篩選及抑菌譜測定
從采集的土壤中分離純化后共獲得96株芽胞桿菌,通過對峙培養篩選到1株具有較好拮抗作用的菌株(圖1),編號為L249。該菌對5種植物病原真菌均具有良好抑制作用,抑制率均在60.00%以上(表2),其中對鏈格孢菌的抑制效果最好,抑制率達72.27%。
圖1菌株L249對4種植物病原真菌的抑制作用

表2菌株L249對5種病原真菌的抑制作用①
培養7 d后,挑取鏈格孢菌菌絲在蔡司顯微鏡下觀察,發現對照菌絲挺直,粗細均勻,而與L249對峙培養后,菌絲出現粗細不均勻、旋轉結節及腫大等現象(圖2)。

圖2菌株L249對鏈格孢菌的拮抗效果
A.鏈格孢菌單獨培養B.菌株L249與鏈格孢菌對峙培養C.單獨培養的鏈格孢菌菌絲(100×)D.與L249對峙培養7d后的鏈格孢菌菌絲(100×)
2.2生長曲線測定
生長速率測定結果表明(圖3),菌株L249在0~2 h內生長較慢,處于延滯期,2~4 h生長逐漸加快,4 h后生長速率劇增,進入對數生長期,4~6 h生長速率最快,6~14 h菌株生長量持續增加,14 h后OD600值達到最大。培養16~26 h后菌株生長量基本保持不變,到達穩定期,26 h以后開始下降,進入衰亡期。

圖3菌株L249的生長曲線
2.3生物膜和生防相關酶類檢測
如圖4所示,菌株L249在液氣交界處能形成復雜的生物膜結構,可在蛋白酶和纖維素酶平板上產生透明消解圈,表明該菌可產生蛋白酶和纖維素酶。

圖4菌株L249菌落形態、生物膜、蛋白酶和纖維素酶檢測
2.4拮抗菌L249鑒定
2.4.1菌落形態及生理生化特性
菌落形態觀察發現(圖4),菌株L249在LB培養基平板上呈乳白色,菌落表面有褶皺,邊緣不整齊。菌株的生理生化特征如表3所示,菌株L249革蘭氏染色為紫色,能產生多種水解酶,明膠液化、甲基紅試驗及V-P試驗等反應均呈陽性,檸檬酸鈉鹽利用、苯丙氨酸脫氫酶和吲哚試驗等反應均呈陰性且具有較好的耐鹽性。

表3菌株L249的生理生化特征①
2.4.2系統發育分析
基于16S rDNA和gyrA基因序列構建了菌株L249的多基因系統發育樹(圖5),結果顯示菌株L249與枯草芽胞桿菌(Bacillus subtilis NRRL B-4219*)聚為一支,且支持率為100%,結合其形態特征、生理生化特性及系統發育分析,將其鑒定為枯草芽胞桿菌(Bacillus subtilis)。菌株L249的16S rDNA和gyrA基因序列已提交GenBank數據庫,登錄號分別為MT786346和MT802123。

圖5基于16S rDNA和gyrA基因序列構建的進化樹
2.5盆栽防病試驗
盆栽試驗結果表明(表4),L249發酵液對煙草赤星病具有明顯防治效果,經其處理后煙株發病率和病情指數均顯著低于對照,相對防效為60.66%,與10%苯醚甲環唑WDG的相對防效無顯著差異。

表4拮抗菌L249發酵液對煙草赤星病的盆栽防治效果①
3討論
本研究中從煙草根際分離得到一株具有較好拮抗作用的枯草芽胞桿菌L249,該菌對鏈格孢菌、高粱葉點霉菌、大斑突臍蠕孢菌、煙草炭疽菌及尖孢鐮孢菌等5種病原真菌均有一定抑制作用,表現出良好的廣譜抑菌活性,具有潛在的生防利用價值,這與王欣悅等對枯草芽胞桿菌抑菌機制的研究結果一致。對峙培養觀察發現,枯草芽胞桿菌L249可以有效抑制鏈格孢菌生長并造成菌絲生長稀疏和膨大畸形,這與任建雯研究貝萊斯芽胞桿菌B56與鏈格孢菌對峙培養后,菌絲也出現斷裂增多、膨大畸形及生長速度變慢等現象相似。本研究中還發現枯草芽胞桿菌L249能形成生物膜,可產生蛋白酶、纖維素酶及硝酸還原酶等生防相關酶類降解病原真菌細胞壁從而抑制病原菌生長,這與馬佳等研究解淀粉芽胞桿菌(Bacillus amyloliquefaciens)B501抑菌機制的結果相符。枯草芽胞桿菌L249生長曲線結果表明,該菌延滯期短,4 h就進入對數生長期,14 h便達到最大生物量。菌株發酵時間短、生物量大及活力強,可節約生產成本,為今后工業化應用提供了理論依據。
本研究中測定了煙草赤星病的室內盆栽防效,結果發現,菌株L249發酵液處理煙葉后,可顯著降低煙草赤星病的病情指數,相對防效達60.66%,與羅楚翔等和葉愛萍等研究枯草芽胞桿菌對煙草赤星病的室內防效相比存在一定差異,推測這可能與供試枯草芽胞桿菌來源不同有關。除對煙草赤星病有較好防治效果外,枯草芽胞桿菌對其他植物病害也有良好防治效果。本試驗僅用枯草芽胞桿菌L249對煙草赤星病進行室內防效測定,該菌對其他植物病害是否也具有較好的防治效果還有待進一步驗證。
4結論
從貴州省清鎮市衛城鎮煙區健康煙草根際土壤中分離到一株對鏈格孢菌有明顯拮抗作用的菌株L249,經鑒定為枯草芽胞桿菌。該菌能有效抑制鏈格孢菌菌絲生長并造成菌絲膨大畸形,且對高粱葉點霉菌、大斑突臍蠕孢菌、煙草炭疽菌及尖孢鐮孢菌等4種病原真菌也有一定抑制作用。該菌生長速度快,培養14 h可達到最大生長量。菌株L249能產生形態結構復雜的生物膜,能產蛋白酶、纖維素酶及硝酸還原酶等生防相關酶類,盆栽試驗表明其發酵液可有效降低煙草赤星病的病情指數。
相關新聞推薦
3、產脂肪酶地衣芽孢桿菌LD-1302篩選、培養基及產酶條件研究(一)
